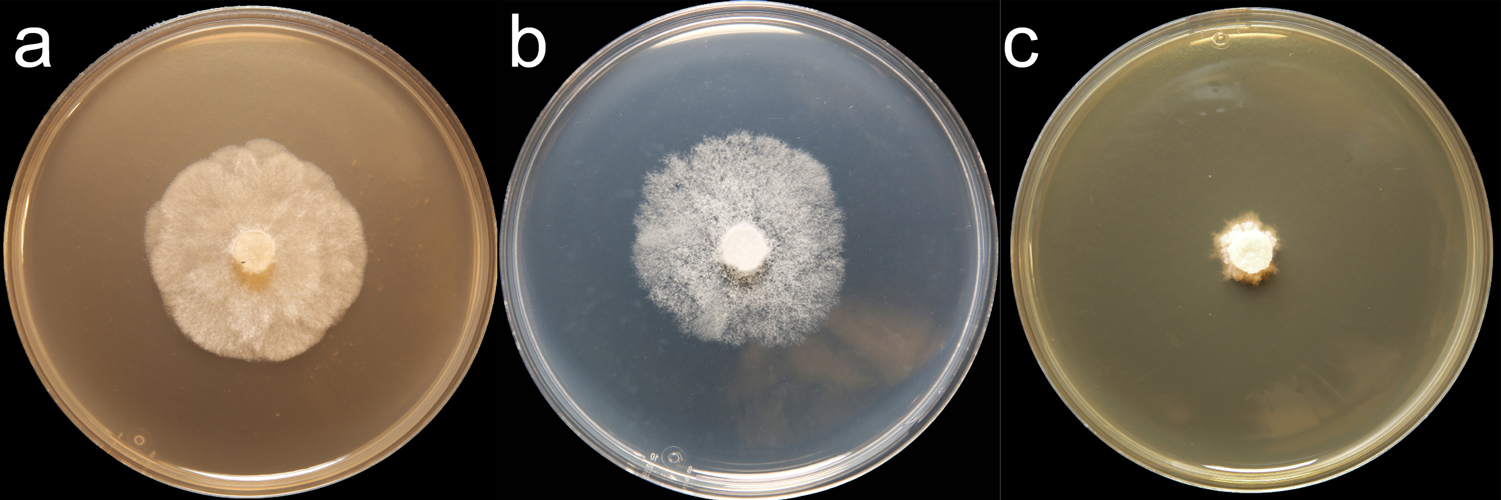

Phytophthora nemorosa
|
Phytophthora spp. in Clade 3: portion of the seven-loci ML phylogeny featuring the type cultures of 212 described species (by T. Bourret). Notice the position of P. nemorosa Ex-type CBS 114870 = S&T BL 27. Gloria Abad, USDA S&T.
|
|
Phytophthora spp. in Clade 3: Morphological Tabular key (PDF) and Tabular key legends (PDF) in IDphy2 KEY SECTION. Notice the data of P. nemorosa Ex-type CBS 114870 = S&T BL 27. Gloria Abad, USDA S&T.
|
|
Phytophthora nemorosa (CPHST BL 167) colonies of a selected specimen grown for 7 days on (a) V8® Agar, (b) potato dextrose agar, and (c) malt extract agar; photo by Krysta Jennings and Leandra Knight, USDA-APHIS-PPQ |
|
Phytophthora nemorosa (CPHST BL 27) sexual phase (a–c) showing oogonia smooth-walled, amphyginous antheridia, and aplerotic oospores; photo by Gloria Abad. |
|
Phytophthora nemorosa (CPHST BL 27): hyphal swellings; photo by Gloria Abad. |
|
Phytophthora nemorosa (CPHST BL 27) sexual phase: showing oogonium smooth-walled, amphyginous antheridium, and aplerotic oospore; photo by Gloria Abad. |
|
Phytophthora nemorosa (CPHST BL 27) sexual phase: showing oogonium smooth-walled, amphyginous antheridium, and aplerotic oospore; photo by Gloria Abad. |
|
Phytophthora nemorosa (CPHST BL 27) sexual phase: showing oogonium smooth-walled, amphyginous antheridium, and aplerotic oospore; photo by Gloria Abad. |
Name and publication
Phytophthora nemorosa E.M. Hansen & Reeser (2003)
Hansen EM, Reeser PW, Davidson JM, Garbelotto M, Ivors K, Douhan L, and Rizzo DM. 2003. Phytophthora nemorosa, a new species causing cankers and leaf blight of forest trees in California and Oregon, U.S.A. Mycotaxon 88: 129–138 (pg 131).
Nomenclature
from Hansen et al. (2003)
Mycobank
Etymology
refers to the forest setting from which most isolates have been recovered
Typification
Type: UNITED STATES, Humbolt County in California, recovered from tanoak (Lithocarpus densiflorus); type specimen (a dried agar culture) deposited in the Oregon State University Mycological Herbarium (OSC 104381) from isolate P-13
Ex-type: culture MYA-2948 (ATCC) from isolate P-13
Sequences for ex-type in original manuscript: P-13 = ITS rDNA AY332651
Ex-type in other collections
(ET) CBS 114870, ATCC MYA-2948, WPC P19600, S&T BL 27 (Abad), 41C4 (Hong), p320 (Gallegly)
Molecular identification
Voucher sequences for barcoding genes (ITS rDNA and COI) of the ex-type (see Molecular protocols page)
Phytophthora nemorosa isolate CPHST BL 27 (= P19600 WPC) = ITS rDNA MG865548, COI MH136941
Sequences for selected specimen
Phytophthora nemorosa isolate CPHST BL 167 (= P10288 WPC) = ITS rDNA MG865549, COI MH136942
Voucher sequences for Molecular Toolbox with seven genes (ITS, β-tub, COI, EF1α, HSP90, L10, and YPT1
(see Molecular protocols page) (In Progress)
Voucher sequences for Metabarcoding High-throughput Sequencing (HTS) Technologies [Molecular Operational Taxonomic Unit (MOTU)]
(see Molecular protocols page) (In Progress)
Sequences with multiple genes for ex-type in other sources
- NCBI: Phytophthora nemorosa CPHST BL 27
- NCBI: Phytophthora nemorosa CBS 114870
- EPPO-Q-bank: Phytophthora nemorosa CBS 114870 (= MYA 2948 = P-13)
- BOLDSYSTEMS: Phytophthora nemorosa (barcoding COI & ITS)
Position in multigenic phylogeny with 7 genes (ITS, β-tub, COI, EF1α, HSP90, L10, and YPT1)
Clade 3
Morphological identification
Colonies and cardinal temperatures
Colony colony:
assemblage of hyphae which usually develops form a single source and grows in a coordinated way
morphology on V-8 agar with rosette pattern, potato dextrose agar with no distinct pattern, and malt extract agar with slow growth. Minimum for growth 3°C, optimum 15–20°C, maximum 21°C.
Conditions for growth and sporulation
Chlamydospores and hyphal swellings are observed in old 10% soil solution water cultures.
Asexual phase
SporangiaSporangia:
sac within which zoospores form, especially when water is cooled to about 10°C below ambient temperature; in solid substrates, sporangia usually germinate by germ tubes
semipapillatesemipapillate:
pertaining to the production of shallow having papilla that are not well developed, shallow and less nipple-like than fully papillate structures
; caducouscaducous:
pertaining to sporangia that become dislodged readily (i.e. deciduous) and separate from the sporangiophore (cf. persistent)
with medium to long pedicelpedicel:
the hyphal base of a sporangium that remains attached after the sporangium separates, or is shed, from the sporangiophore; the pedicel may be short (< 5 µm), medium (5–20 µm), or long (> 20 µm)
(5–20 µm L); ellipsoidellipsoid:
refers to a solid body that forms an ellipse in the longitudinal plane and a circle in cross section; many fungal spores are ellipsoidal or elliptic
, ovoidovoid:
egg-shaped, with the widest part at the base of the sporangium and the narrow part at the apex
, obpyriformobpyriform:
inversely pear-shaped, i.e. with the widest part at the point of attachment (cf. pyriform)
, obovoidobovoid:
inversely egg-shaped; ovoid, but with the widest part at the apex
, obturbinate, (27–64 L x 19–45 W µm), but predominantly ovoidovoid:
egg-shaped, with the widest part at the base of the sporangium and the narrow part at the apex
or irregular in shape (asymmetrical, kidney-shaped); originated in simple sympodial or branched sporangiophores. Hyphal swellings globoseglobose:
having a rounded form resembling that of a sphere
, sub-globose, ellipsoidellipsoid:
refers to a solid body that forms an ellipse in the longitudinal plane and a circle in cross section; many fungal spores are ellipsoidal or elliptic
and intercalaryintercalary:
positioned within a hypha (cf. terminal)
, many times with radiating hyphaehyphae:
single, tubular filament of a fungal or oomycete thallus; the basic structural unit of a fungus or oomycete
and often produced in chains. ChlamydosporesChlamydospores:
an asexual spore with a thickened inner wall that is delimited from the mycelium by a septum; may be terminal or intercalary, and survives for long periods in soil
globoseglobose:
having a rounded form resembling that of a sphere
and sub-globose (18–41 µm diam.), terminally, intercalaryintercalary:
positioned within a hypha (cf. terminal)
, or catenulated.
Sexual phase
Homothallic. OogoniaOogonia:
the female gametangium in which the oospore forms after fertilization by the antheridium
smooth-walled (18–42 µm diam.) occasionally with tapered bases, and may have somewhat wavy walls; antheridiaantheridia:
the male gametangium; a multinucleate, swollen hyphal tip affixed firmly to the wall of the female gametangium (the oogonium)
amphyginous (11–21 x 10–15 µm); oospores aplerotic, pleroticplerotic:
pertaining to an oospore that fills the oogonium (cf. aplerotic)
, or slightly apleroticaplerotic:
pertaining to a mature oospore that does not fill the oogonium; i.e. there is room left between the oospore wall and oogonium wall (cf. plerotic)
(16–35 µm diam.).
Specimen(s) evaluated
Phytophthora nemorosa ex-type CPHST BL 27, duplicate of P19600 (World Phytophthora Collection), which is a duplicate of ex-type MYA-2948
Hosts and distribution
Distribution: North America (CA, OR)
Substrate: leaves, bark of boles
Disease note: lethal bole canker of oaks, foliar necrosis. It co-occurs with Phytophthora ramorum, but is often associated with a single tree rather than patch mortality (Hansen et al. 2003).
Host: various families, including the Fagaceae Lithocarpus densiflorus (tanoak) and Quercus agrifolia (live oak)
Retrieved January 31, 2018 from U.S. National Fungus Collections Nomenclature Database.
Additional references and links
- SMML USDA-ARS: Phytophthora nemorosa
- EPPO Global Database: Phytophthora nemorosa
- Forest Phytophthoras of the world: Phytophthora nemorosa
- CABI Digital Library: Phytophthora nemorosa
- Encyclopedia of Life (EOL): Phytophthora nemorosa
- Index Fungorum (IF): Phytophthora nemorosa
- Google All Phytophthora nemorosa
- Google Scholar Phytophthora nemorosa
- Google Images Phytophthora nemorosa
Fact sheet author
Z. Gloria Abad, Ph.D., USDA-APHIS-PPQ-S&T Plant Pathogen Confirmatory Diagnostics Laboratory (PPCDL), United States of America.